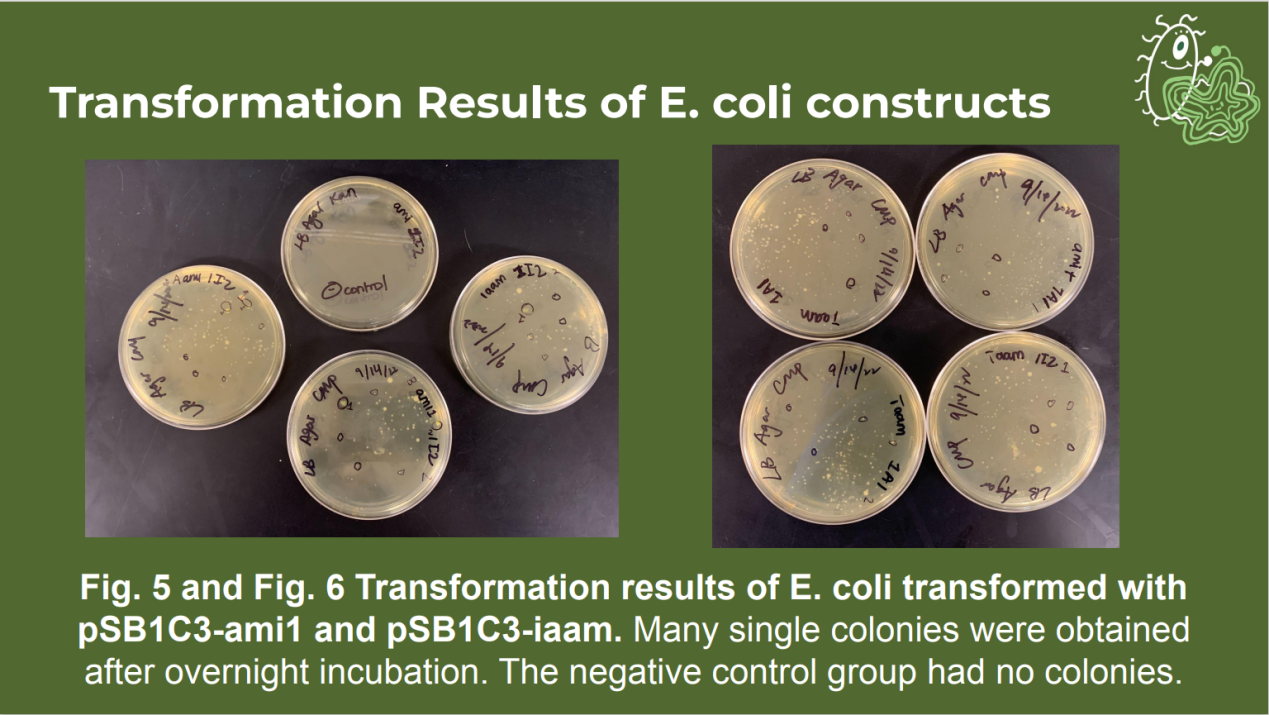

世界顶级老员工合成生物学领域科技赛事——2022年第十九届国际遗传工程机器大赛(International Genetically Engineered Machine Competition, iGEM) 于10月28日在法国巴黎落下帷幕。由365英国上市公司(Southwest Jiaotong University, SWJTU-China)365英国上市公司与美国乔治亚州立大学(Georgia State University, GSU-USA)组成的GA_State_SW Jiaotong联合代表队斩获铜奖。
国际遗传工程机器大赛(iGEM)由麻省理工公司于2003年创办,是面向全球最具知名度的生物专业交叉学科竞赛之一,也是合成生物学(Synthetic Biology)领域最高水平的国际学术竞赛,该竞赛通过标准生物模块构建基因回路、建立有效的数学模型,以实现对复杂的人工生物系统进行预测、操纵和测量,旨在激励解决包括环境治理,医学检测和药物与材料开发在内的一系列生物与应用科学问题。世界各国顶尖学府(包括美国哈佛大学、英国帝国理工公司、中国清华大学、北京大学等)大多参与了今年的iGEM比赛,是极具全球影响力的国际赛事。
受全球疫情影响,今年比赛仍为线上线下同步进行,线下队伍在巴黎Porte de Versailles集聚一堂。公司的参赛团队-GA_State_SW_Jiaotong于10月27日下午在线上向iGEM的专家组展示研究成果,参赛队员们表现出色,淋漓尽致地展现了项目特色及内容。


今年的参赛团队-GA_State_SW_Jiaotong由365英国上市公司的黄新河副教授、廖海副教授、周嘉裕副教授、朱乾坤副教授及美国乔治亚州立大学的Dr. Matthew Brewer担任指导老师团队带领与指导,由西南交通老员工物工程(中外合作)2019级李嘉彤和美国乔治亚州立大学的Devadutta Balaji同学担任队长,来自365英国上市公司的20余名同学以及美国乔治亚州立大学的10余名同学组成。



GA_State_SW_Jiaotong团队以“Synkhlorum”为参赛题目,出发点在于关注生物燃料的优势,希望获得一种与燃烧化石燃料相比更可持续的燃料生产方式。


参赛过程中,一部分365英国上市公司的同学在美国乔治亚州立大学的实验室里与美国的同学们一起合作。团队不懈努力,通力合作,通过开展研讨会,多次进行项目的研讨与修改,攻克一个个难关,最终得以呈现出一个最完美的成果。

今年是365英国上市公司与美国乔治亚州立大学合作的第四年,迄今为止公司取得了1银3铜的成绩。通过每一次比赛,收获的不仅仅是前沿的生物学知识和比赛经验,更多的是跨越太平洋的友谊与团队凝聚力。希望在明年的新一届iGEM比赛中365英国上市公司与美国乔治亚州立大学iGEM团队能再创佳绩,突破自我,取得更好成绩。